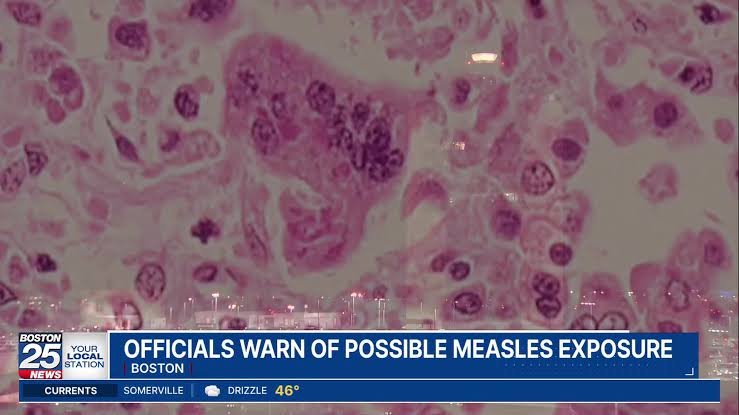
Traveler with measles recently passed through Boston’s Logan Airport, officials warn

BOSTON — State and local officials issued an urgent public health warning on Wednesday morning regar...
Traveler with measles recently passed through Boston’s Logan Airport, officials warn
BOSTON — State and local officials issued an urgent public health warning on Wednesday morning regarding a person with measles who passed through Boston's...
Author: Boston 25 News
Read Original Article









































